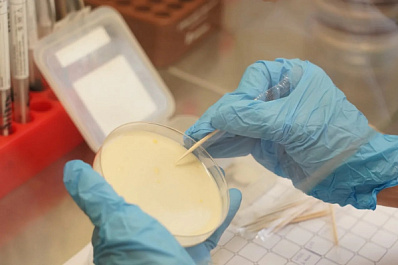

Региональный этап Знание.Игра (12+) проходит согласно расписанию по федеральным округам. В рамках соревновательного дня Приволжского федерального округа приняли участие более 1300 школьников и студентов колледжей.
Победитель в каждом субъекте РФ получит право выступить в очном финале турнира, который состоится 15 мая 2026 года в Москве. Масштабное событие объединит до 500 участников. По результатам финальной игры турнира будут награждены 10 команд: 1 абсолютный победитель состязания, а также 9 призеров. Все они получат ценные подарки от партнеров события.
Турнир Знание.Игра входит в перечень мероприятий Минпросвещения России, ежегодно рекомендуемых к реализации в рамках календарного плана воспитательной работы. Помимо направления викторин, в сезоне 2025–2026 гг. продолжается Турнир по спортивному "Что? Где? Когда?" (12+) по лицензии правообладателя. К участию в нем приглашаются команды в двух возрастных категориях: школьники и студенты СПО (14–18 лет) и студенты вузов и работающая молодежь (18–25 лет). В направлении викторин, помимо трека для школ и колледжей, также проходит соревнование для студентов вузов, где команды до 5 человек могут проверить свою логику и эрудицию в вопросах от ребусов до шарад.
Подробная информация об интеллектуальных соревнованиях размещена в сообществе Знание.Игра ВКонтакте.
24.04.2026 | 11:33
Юные знатоки из Самарской области прошли в финал турнира Знание.Игра по викторинам среди школьников и студентов колледжей
Команда из Средней общеобразовательной школы им. Н. Ф. Зыбанова м. р. Кинель-Черкасский Самарской области с. Березняки прошла в финал Турнира Знание.Игра по викторинам среди школьников и студентов колледжей. Они и еще 90 команд эрудитов из 89 регионов России, а также из Республики Абхазия и Республики Беларусь встретятся 15 мая в Москве, в Национальном центре "Россия". Всего для участников масштабнейшего интеллектуального соревнования было организовано 20 отборочных игр.

Следите за нашими новостями в удобном формате
Перейти в Дзен